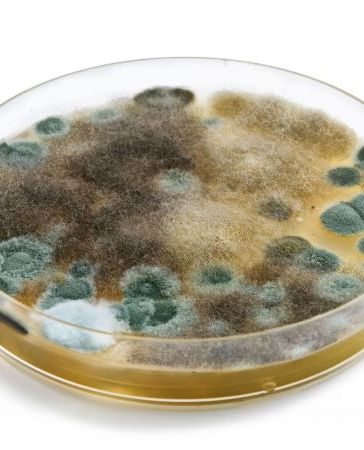

Schimmelpilzschäden Erkennen und Bewerten
Mit Sachverstand gegen Verharmlosung oder Panikmache!
Als Ihr Bausachverständiger und Gutachter für Bau-, Feuchte- und Schimmelpilzschäden in Düsseldorf biete ich Ihnen unabhängigen Sachverstand anstatt Panikmache und Verharmlosung. Die Schimmelpilzproblematik hat in den letzten 25 Jahren stark zugenommen. In der Diskussion trifft dann häufig extreme Verharmlosung auf übertriebene Panikmache.
Wirtschaftliche Interessen kommerzieller Produktanbieter spielen ebenfalls eine große Rolle bei der Einschätzung des Schimmel-Problems. Hier bedarf es eines neutralen und sachkundigen Fachmanns, der auf Basis neuester Erkenntnisse die Schadensursachen analysiert.
Möchten Sie einen Termin vereinbaren oder haben Sie noch weitere Fragen? Dann rufen Sie mich unter 0211-40 8000 9 an oder nutzen Sie das Kontaktformular - gerne stehe ich Ihnen mit einer individuellen Beratung und einem ausführlichen Gutachten zur Seite
Schimmelpilz-Was ist Das?
Schimmelpilze ist ein Sammelbegriff für Pilze, die typische Pilzfäden und Sporen ausbilden können. Schimmelpilze bilden in der Wachstumsphase Zellfäden. Diese sind meist farblos, so dass der Schimmelpilz in dieser Phase normalerweise mit dem bloßen Auge nicht erkennbar ist.
Zur Vermehrung und Verbreitung bilden Schimmelpilze Sporen . Diese sind oft gefärbt, so dass der Schimmelpilzbefall in diesem Stadium auch mit bloßem Auge (zum Beispiel als schwarze oder gelbe Schimmelpilzflecken) erkennbar ist.
Das Schimmelpilzwachstum im Innenraum wird hauptsächlich durch drei Faktoren bestimmt: Feuchtigkeit, Nährstoffangebot und Temperatur.
Schimmelpilze sind ein natürlicher Teil unserer belebten Umwelt. Ihre Sporen sind fast überall zu finden, also auch in Innenräumen. Sie sind normalerweise harmlos. Übersteigt allerdings die Schimmelpilzkonzentration ein bestimmtes Maß, kann es zu gesundheitlichen Problemen für die Bewohner kommen.

Schimmelpilze können auf Materialien nur wachsen, wenn eine bestimmte Mindestfeuchte vorhanden ist. Dabei ist nicht die Gesamtfeuchte des Materials ausschlaggebend, sondern nur das den Pilzen zur Verfügung stehende freie Wasser. Schimmelpilze können auch auf und in Materialien wachsen, die nicht sichtbar nass sind. Es genügt eine relative Luftfeuchtigkeit von ungefähr 55 - 80 % an der Oberfläche des Materials. Besonders gute Wachstumsbedingungen finden sich immer dann, wenn es zu Tauwasserbildung auf oder im Material kommt.
Möchten Sie einen Termin vereinbaren oder haben Sie noch weitere Fragen? Dann rufen Sie mich unter 0211-40 8000 9 an oder nutzen Sie das Kontaktformular – gerne stehe ich Ihnen mit einer individuellen Beratung und einem ausführlichen Gutachten zur Seite
Schimmel und Gesundheit
Zahlreiche Studien zu den gesundheitlichen Auswirkungen von Schimmelpilzen sehen einen Zusammenhang zwischen der Belastung mit Schimmelpilzen und Atemwegsbeschwerden. Sporen und Stoffwechselprodukte von Schimmelpilzen können, über die Luft eingeatmet, allergische und reizende Reaktionen beim Menschen auslösen. In keiner dieser Studien konnte jedoch bislang festgestellt werden, ab welcher Konzentration an Schimmelpilzen in der Luft mit gesundheitlich negativen Auswirkungen gerechnet werden muss. Es wird angenommen, dass grundsätzlich alle Schimmelpilze in der Lage sind, allergische Reaktionen bei dafür empfänglichen Personen auszulösen. Bei Allergien setzt sich das Immunsystem des Körpers nicht gegen gefährliche Fremdstoffe (zum Beispiel Krankheitserreger), sondern fälschlicherweise gegen an sich harmlose Fremdstoffe (wie zum Beispiel Pollen, Bestandteile von Lebensmitteln) zur Wehr. Beim ersten Kontakt mit dem Fremdstoff (Antigen) tritt noch keine allergische Reaktion auf, sondern der Körper bereitet sich durch die Produktion von Abwehrstoffen (Antikörpern) auf die Bekämpfung des vermeintlichen Schädlings vor. Man bezeichnet eine solche Person als „sensibilisiert“. Erst bei erneutem Kontakt mit dem Fremdstoff kann es dann zu allergischen Erscheinungen kommen, bei denen eine ganze Kette von Reaktionen im Körper abläuft, an deren Ende die typischen Symptome allergischer Reaktionen, wie Schnupfen, Niesen, gerötete Augen, Hautausschlag etc. stehen. Die häufigsten bei Schimmelpilzbelastungen im Innenraum beschriebenen Symptome sind unspezifisch, so zum Beispiel Bindehaut-, Hals- und Nasenreizungen sowie Husten, Kopfweh oder Müdigkeit. Infektionen durch Schimmelpilze (Mykosen) kommen nur sehr selten und nur bei besonders empfänglichen, stark immungeschwächten Personen vor. Allergische und reizende Wirkungen können sowohl von lebenden als auch von abgestorbenen Schimmelpilzen ausgehen, während zur Auslösung von Infektionen nur lebende Schimmelpilze befähigt sind.
Schimmel in der Wohnung: Gesundheitsschäden bei Kindern
Vor allem seiner Kinder zuliebe sollte man jedes kleine Anzeichen für Schimmelbefall ernst nehmen und entsprechend reagieren. Denn Kinder, die dauerhafter Sporenbelastung in einer schimmelnden Wohnung ausgesetzt sind, reagieren besonders empfindlich. Außerdem können sie mögliche Beschwerden nicht in jedem Fall mitteilen. Um solche gesundheitlichen Beeinträchtigungen zu vermeiden, ist rasches Handeln oberstes Gebot, wenn Sie Schimmelbefall entdecken.
Mit Sachverstand geben Verharmlosung und Panikmache
Die Schimmelpilzproblematik hat in den letzten 25 Jahren stark zugenommen. In der Diskussion trifft dann häufig extreme Verharmlosung auf übertriebene Panikmache.
Wirtschaftliche Interessen kommerzieller Produktanbieter spielen ebenfalls eine große Rolle bei der Einschätzung des Schimmel-Problems. Hier bedarf es eines neutralen und sachkundigen Fachmanns, der auf Basis neuester Erkenntnisse die Schadensursachen analysiert.
Grundsätzlich gilt das Minimierungsgebot, das heißt ein Schimmelbefall in Wohnräumen ist aus hygienischen Gründen nicht zu tolerieren. Die Ursache für den Schimmelbefall ist zu ermitteln und fachgerecht nachhaltig zu beseitigen.
Als Ihr Bausachverständiger für Bau-, Feuchte- und Schimmelpilzschäden in Düsseldorf biete ich Ihnen unabhängigen Sachverstand anstatt Panikmache oder Verharmlosung.
Möchten Sie einen Termin vereinbaren oder haben Sie noch weitere Fragen? Dann rufen Sie mich unter 0211-40 8000 9 an oder nutzen Sie das Kontaktformular – gerne stehe ich Ihnen mit einer individuellen Beratung und einem ausführlichen Gutachten zur Seite
Was tun, wenn der Schimmel entdeckt ist?
Sie haben einen Schimmelpilzbefall in Ihren Wohnräumen entdeckt. Jetzt stellt sich die Frage: "Was ist zu tun?".
1. Dokumentieren
Halten Sie den aktuellen Schimmelpilzbefall fotografisch fest. Zusätzlich sollten Sie die folgenden Parameter aufnehmen: Außentemperatur, Raumtemperatur und die relative Luftfeuchtigkeit im betroffenen Zimmer. Diese Daten können für die nachträgliche Analyse der Schadensursache sehr hilfreich sein.
Auf den Einsatz aggressiver chemischer Mittel sollten die Bewohner verzichten. Viele dieser „Chemiekeulen“ sind gesundheitsschädlich.
2. Abkleben
Kleben Sie den Befall luftdicht mit Hilfe einer Folie ab. Schneiden Sie die Folie passend zurecht, am besten 0,5 m um die kontaminierte Stelle hinaus. Mit einem Klebeband (Gewebeklebeband oder Klebeband für Dampfsperren) rundum die Folie an der Wand festkleben. Die Folie soll den Schimmelpilz luftdicht einschließen.
Durch das Abkleben verhindern Sie die weitere Verteilung der Sporen durch Luftaufwirbelungen im Raum.
3. Den Raum meiden
Den von Schimmelpilzen kontaminierten Raum wenn möglich meiden. Halten Sie sich nicht länger als unbedingt notwendig dort auf. Sollte der Schimmelpilzbefall in Ihrem Schlafzimmer sein, empfehlen wir dringend, sich bis zur Sanierung eine andere Schlafstätte zu suchen.
Schimmelpilzsporen auf Dauer einzuatmen ist gesundheitlich höchst bedenklich und kann zu chronischen Atemwegserkrankungen führen.
4. Grünewald Bausachverständigen kontaktieren
Um eine fachmännische Einschätzung des Schadens zu erhalten, sollten Sie sich umgehend an mich wenden (0211- 4080009 ). Ich kann den Schimmelpilzschaden Einschätzen und eine entsprechende Sanierung von Schimmelpilzschäden empfehlen.
Fehler die Sie unbedingt bei bei Schimmelpilzbefall vermeiden sollten!
Auch die häufig empfohlene Essiglösung ist nicht empfehlenswert für das Bekämpfen von Schimmel. Sie verliert ihre Wirkung, wenn sie mit alkalischen Stoffen wie Kalk, der in vielen Innenputzen steckt, in Berührung kommt. Außerdem enthält Essig organische Nährstoffe, die das Pilzwachstum sogar begünstigen können.
Befallene Tapeten, Gipskartonplatten oder Holzteile müssen entsorgt werden. Zusätzlich sollten Vorhänge oder abnehmbare Möbelbezüge nach der Schimmelbeseitigung gereinigt werden.
Schwerer Schimmelbefall ist eine Sache für den Profi
Großflächiger Schimmelbefall zum Beispiel nach Leitungswasserschäden ist in jedem Fall eine Aufgabe für den Spezialisten. Eine solcher Fachfirma verfügt über eine entsprechende Ausrüstung und kennt sich mit den Problemen und Gefahren der Schimmelbeseitigung aus. Solche Fachfirmen verfügen zum Beispiel über eine Spezialausrüstung zum Abfräsen von Putzschichten, Spezialsauger und Luftschleusen.
Als Ihr Bausachverständiger für Bau-, Feuchte- und Schimmelpilzschäden in Düsseldorf biete ich Ihnen unabhängigen Sachverstand anstatt Panikmache und Verharmlosung.
Wichtig für Mieter:
Der Deutsche Mieterbund (DMB) rät aus mietrechtlichen Gründen davon ab, den Schimmel auf eigene Faust zu bekämpfen. Wenn Mieter das Schimmelproblem selbst angehen, ohne die eigentliche Schadensursache zu kennen, riskieren sie, dass der Schimmel wiederkommt und sich die Feuchtigkeitsschäden verschlimmern. Dann sind sie sogar zum Schadensersatz verpflichtet. „Deshalb sind Mieter verpflichtet, Schimmel in der Wohnung sofort dem Vermieter mitzuteilen. Bei oberflächlichen, rein kosmetischen Lösungsversuchen ist Vorsicht geboten“, warnt Ulrich Ropertz vom DMB.
Möchten Sie einen Termin vereinbaren oder haben Sie noch weitere Fragen? Dann rufen Sie mich unter 0211-40 8000 9 an oder nutzen Sie das Kontaktformular – gerne stehe ich Ihnen mit einer individuellen Beratung und einem ausführlichen Gutachten zur Seite.
Ursachen für Feuchte- und Schimmelschäden

Eine Schimmelpilzsanierung ohne Beseitigung der Ursachen ist allerdings nicht sinnvoll, da früher oder später mit einem erneuten Schimmelpilzwachstum zu rechnen ist.
Daher ist es unerlässlich, die Ursachen für das Schimmelpilzwachstum, insbesondere die Frage eines erhöhten Feuchteeintritts, zu klären. Schimmelpilze benötigen zum Wachsen viel Feuchtigkeit. Ursachen erhöhter Feuchte innerhalb von Gebäuden können zum Beispiel sein:
- direkter Eintrag von Feuchtigkeit zum Beispiel über:
- defekte Dächer (insbesondere Flachdächer), Dachrinnen und Fallrohre;
- Risse im Mauerwerk;
- ungenügendes Austrocknen nach Baumaßnahmen;
- Wassereintritt infolge Rohrbrüchen, Überschwemmungskatastrophen etc.
- unzureichende Abfuhr erhöhter Raumluftfeuchte durch:
- unsachgemäßes Heizen und Lüften, insbesondere in luftdichten Gebäuden.
- Kondensation (Tauwasserbildung) von Luftfeuchte im Bereich von kalten
Wänden, die wegen unzureichender Wärmedämmung in manchen
Altbauten ein Problem darstellen. Baufehler wie Wärmebrücken führen
ebenfalls in Neu- und Altbauten zur Wasserdampfkondensation entlang
der Bauschadensbereiche.
Die Aufstellung zeigt, dass neben baulichen und bauphysikalischen Mängeln, auch die Bewohnerinnen und Bewohner zu erhöhter Feuchte im Gebäude beitragen. Unsachgemäßes Lüften in Verbindung mit Tätigkeiten, bei denen viel Feuchtigkeit entsteht (Duschen, Kochen, Wäschetrocknen, Betrieb großer Aquarien etc.), kann die Feuchtigkeit im Gebäude über das erträgliche Maß hinaus erhöhen. Dies wird vor allem dann ein Problem, wenn die Gebäude aus Energiespargründen aufwändig abgedichtet wurden.
Analyse und Untersuchungen

- Messung des Raumklimas
- Ortung von Wärmebrücken
- Messung der Luftfeuchtigkeit
- Lufttemperatur Oberflächentemperatur mit Wärmebildkamera
- Fotodokumentation der maßgeblichen Schadensbilder
- Messwertinterpretation/Materialprobenentnahme
- Ursachenforschung von Schimmelpilzbildung
- Aufstellen eines Sanierungskonzept-Bestimmung von Schimmelpilzarten (Analytik)
- Bestimmung von Sporen und Keimen in der Raumluft MVOC
- Messungen zum Nachweis von nicht sichtbarem Schimmelbefall Wärmedämm- und Dampfdiffusionsberechnung für Bauteile. Gem. DIN 4108 Teil 5.
Schimmel-Gutachten für Wen und Warum?
Mieter:
Mieter haben nach §537 BGB das Recht auf einen mangelfreien Mietgegenstand. Hat eine Wohnung Schimmelpilzprobleme, werden wir die Ursache herausfinden und selbstverständlich auch die Schuldfrage klären. In einem Kurzgutachten erhält der Mieter sämtliche relevanten Messergebnisse, eine schriftliche Bewertung der Situation und Rat beim Umgang mit seinem Vermieter.
Vermieter:
Mieter haben ihrem Vermieter gegenüber eine Obhutspflicht nach §§ 535, 536 BGB für die angemietete Wohnung. Mit Hilfe verschiedener Messgeräte werden die Ursachen und das Ausmaß des Schimmelbefalls festgestellt . Mit einer Langzeitmessung und anschließender Auswertung der aufgezeichneten Daten wird das Heiz- und Lüftungsverhalten der Mieter über einen längeren Zeitraum dokumentiert . In der abschließenden gutachterlichen Stellungnahme erhält der Vermieter alle Werte und Erkenntnisse in Schriftform. Auf Wunsch erstellen wir ein Konzept für eine nachhaltige Sanierung.
Hauseigentümer:
Hauseigentümer bzw. Bauherren haben das Recht auf eine mangelfreie Werkleistung nach § 631 BGB. Sollten Feuchteschäden durch eine der bauausführenden Handwerksfirmen entstanden sein, werden wir im Rahmen einer Ortsbegehungen die ausgeführten Handwerksleistungen überprüfen und in einer gutachterlichen Stellungnahme schriftlich zusammenfassen. Selbstverständlich erhalten Sie Vorschläge zur Mängelbeseitigung.

